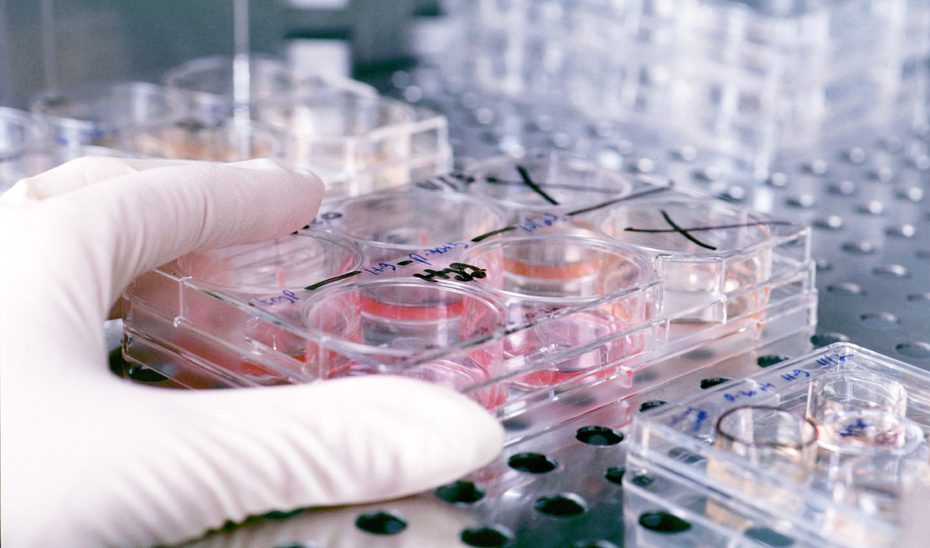
Andalucía alcanza su máximo histórico en inversión en I+D con más de 2.300 millones en 2024

Andalucía ha alcanzado por segundo año consecutivo el mejor dato de su historia en inversión en I+D, con un volumen de 2.310 millones de euros durante el ejercicio 2024, tal y como se desprende del informe sobre ‘Actividades de I+D en Andalucía 2024’, elaborado por la Agencia para la Calidad Científica y Universitaria de Andalucía (ACCUA), adscrita a la Consejería de Universidad, Investigación e Innovación, a partir de los datos publicados por el INE.
Ese desembolso supone un incremento del 1,06%, es decir, 24 millones más, en relación con 2023, cuando se registraron unas cotas significativamente elevadas con respecto a los años anteriores, cifrándose dicho esfuerzo inversor en 2.285,6 millones en términos absolutos. La cuantía de 2024 supera, por tanto, la trayectoria récord cosechada previamente y permite consolidar a Andalucía como motor científico y tecnológico de España. Además, la región se mantiene como el tercer territorio con mayor gasto en I+D, sólo por detrás de la Comunidad de Madrid y Cataluña, y aporta más del 9,7% a la inversión total nacional, aumentando así su peso en la economía del conocimiento.
Si se compara con el ejercicio 2018, la inversión andaluza en investigación y desarrollo del pasado año representa 830,5 millones adicionales, lo que se traduce en un aumento del 56,1% desde el inicio del Gobierno de Juanma Moreno.
De acuerdo con las estadísticas analizadas y siguiendo la senda de ejercicios anteriores, en Andalucía el esfuerzo en I+D procede, mayoritariamente, del sector público, compuesto por la Administración pública y la enseñanza superior (universidades), que continúa actuando como tractor de la inversión regional. Esta esfera aportó en 2024 el 62,4% de los fondos destinados a esta materia en la comunidad, lo que equivale a 1.442,2 millones de euros, unos fondos que constituyen, además, el segundo mejor dato de la serie histórica, sólo superado ligeramente por lo invertido en 2023.
La inversión media anual realizada por el segmento público en el periodo 2013-2018 fue de 918 millones de euros, mientras que, en los seis años de gobierno de Juanma Moreno, es decir, entre 2019-2024, el gasto medio se ha cuantificado en 1.211 millones de euros, lo que supone una subida del 31,9%.
Por su parte, el segmento privado, que engloba a empresas e instituciones privadas sin fines de lucro, destinó el pasado año a estas actividades 868 millones, el mayor volumen en dos décadas, implicando un alza del 9,8% con respecto al año precedente. El tejido privado adquiere ya un peso del 37,6% en el montante de la inversión regional, confluyendo así con el objetivo de la Ley para el Avance de la Ciencia, la Tecnología y la Innovación para Andalucía (ACTIVA) de aumentar de forma progresiva el protagonismo de la inversión privada sobre la pública en materia de investigación. Ese peso mayoritario de la actividad privada ya es una realidad consolidada en los países más avanzados del entorno europeo y en otras comunidades del resto de España.
Inversión regional en I+D por sectores
Por sectores diferenciados, en 2024, la inversión regional en I+D la encabeza en la comunidad el sector de la enseñanza superior, con 1.013,1 millones, procedentes en gran medida de los recursos aportados por las administraciones públicas como es el caso de la Junta de Andalucía (el 43,9% del total del gasto). Les siguen las empresas, con 861,2 millones (37,3% del global); las administraciones públicas, con 429,2 millones (18,6%); y, por último, las instituciones privadas sin fines de lucro, con 6,5 millones (0,3% del conjunto).
Más de 33.100 personas dedicadas a la I+D en Andalucía
En relación con el potencial humano en materia de investigación, Andalucía sigue siendo la tercera región con mayor número de personas dedicadas a actividades de I+D, alcanzando las 33.133 (en equivalencia a jornada completa) entre personal investigador y técnico y auxiliar. Este indicador se ha visto incrementado en 2024 en 658 personas, un 2,0% más que en el año anterior, y en 8.401 desde 2018.
De acuerdo con el informe de ACCUA, el personal dedicado a la I+D en Andalucía representa el 11,2% del conjunto nacional. La mayoría de este colectivo desempeña su labor en el sector público (68,4%), esencialmente en la universidad, y el resto, el 31,6%, en el segmento privado.
Brecha de género
En Andalucía, el personal de I+D masculino supone el 57,1% (18.919), mientras que el femenino representa el 42,9% (14.214), lo que implica una ligera reducción de la brecha de género respecto a la situación de 2023 del 3%.
Estas diferencias se derivan principalmente del sector privado, ya que el porcentaje de mujeres dedicadas a I+D en el sector público en la comunidad alcanza el valor de 49,3% en 2024, mientras que en el sector privado este porcentaje es del 29,1%.